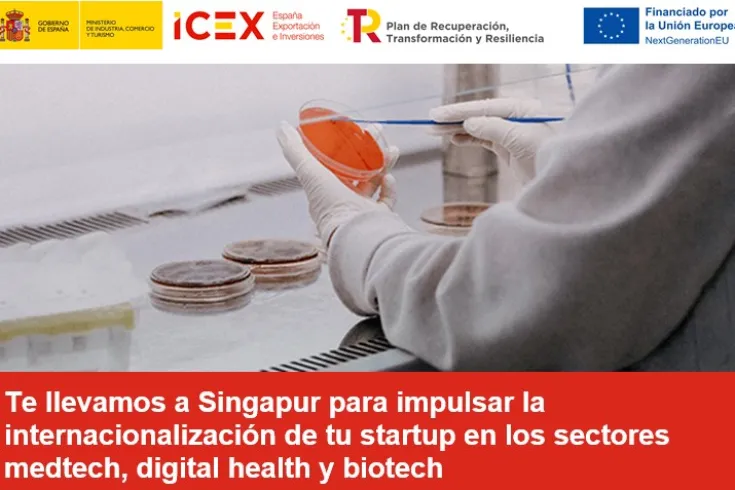
Singapur-ICEX-AseBio-Biotecnologia
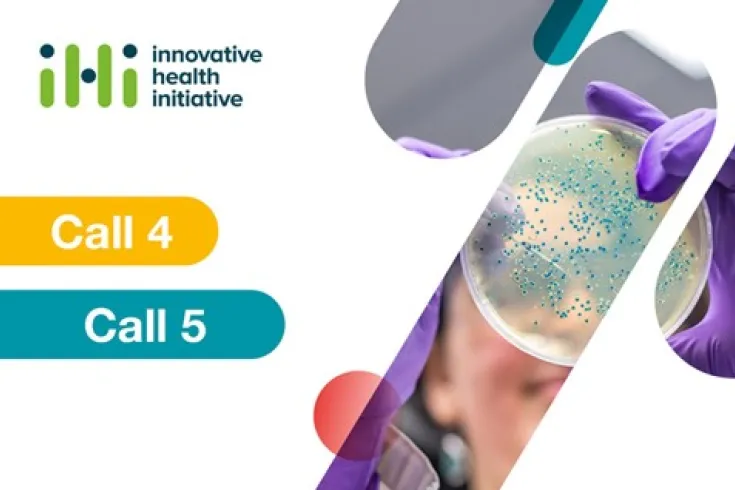
IHICall3-4-Asebio-Biotecnologia

Buscar
Sumario de resultados
TIpos de contenido
Fecha
-
-
-
 Noticia
NoticiaAcceso al mercado: Implicaciones de la tendencia de convergencia regional en Biopharma y M...
La tendencia de convergencia regional en el acceso a los mercados está transformando el panorama de la industria farmacéutica y de MedTechh en Europa
-
-
-
 Noticia
NoticiaLa ciencia: Impulso para la sociedad de hoy
#VozBiotech | Nos encontramos en un momento clave en la historia de la ciencia. En pocos años está teniendo lugar una confluencia de conocimientos, técnicas y circunstancias que los más optimistas
-
Evento
EventoDesafía Sinpagur
-
 Noticia
Noticia3P Biopharmaceuticals aterriza en Estados Unidos
La CDMO biológica navarra inaugura su primera oficina comercial en Boston, con el apoyo de Keensight Capital
-
 Oferta de empleo
Oferta de empleoBusiness developer
-
 Oferta de empleo
Oferta de empleoDoctorando Industrial
-
 Oferta de empleo
Oferta de empleoHead of Administration
-
 Noticia
NoticiaEl Grupo Zendal convoca la IV edición de sus premios dirigidos a reconocer proyectos de s...
Los galardones promovidos tienen como objetivo difundir y potenciar nuevos proyectos de investigación en el campo de la biotecnología
-
 Noticia
NoticiaAsamblea General AseBio Junio 2023
El próximo 20 de junio de 2023 se celebrará la Asamblea General Ordinaria y Extraordinaria, a las 15:00 en primera convocatoria y a las 15:15 en segunda convocatoria.
-
 Noticia
NoticiaReportaje | La biotecnología, motor de cambio ante los desafíos que plantea la alimentació...
En la Semana del Medioambiente, AseBio analiza el papel de la biotecnología ante los retos del sistema agroalimentario, uno de los principales objetivos de BIOSPAIN 2023
-
 Nota de prensa
Nota de prensaLa biotecnología, motor de cambio ante los desafíos que plantea la alimentación del futuro
En la Semana del Medioambiente, AseBio analiza el papel de la biotecnología ante los retos del sistema agroalimentario. De entre los más de 300 socios de AseBio, 60 trabajan en áreas de actividad
-
 Noticia
NoticiaAlmirall y el Centro de Regulación Genómica (CRG) colaboran para desarrollar y caracteriza...
Almirall ha iniciado recientemente una colaboración de investigación con el Centro de Regulación Genómica (CRG), instituto internacional de investigación biomédica de excelencia
-
 Noticia
NoticiaBIOLAN avanza con éxito en el desarrollo del proyecto europeo Aquavitae
BIOLAN está participando en el proyecto AQUAVITAE, financiado por la Comisión Europea, y cuyo objetivo principal es avanzar en la investigación aplicada a la acuicultura
-
 Noticia
NoticiaProductLife Group adquiere Cilatus y amplía su experiencia en el desarrollo de productos c...
Tras las adquisiciones de DS InPharmatics (DSI) en 2021 y Zwiers Regulatory Consultancy en 2022, ProductLife Group (PLG),fortalece aún más sus capacidades para respaldar las actividades de desarrollo
-
 Noticia
NoticiaEl secretoma como medicina del Siglo XXI
La Cátedra UAM-Peaches en Terapias Avanzadas basadas en secretomas celulares, realiza su primera jornada formativa en el campus de la Facultad de Medicina de la UAM
-
 Noticia
NoticiaMSD impulsa la diversidad equitativa en los ensayos clínicos con su campaña ‘Comprometidos...
En el marco de la celebración del Día Internacional del Ensayo Clínico, la compañía biomédica MSD ha lanzado una campaña con el objetivo de visibilizar la importancia de que los ensayos clínicos
-
 Media
Mediaformacion PLG